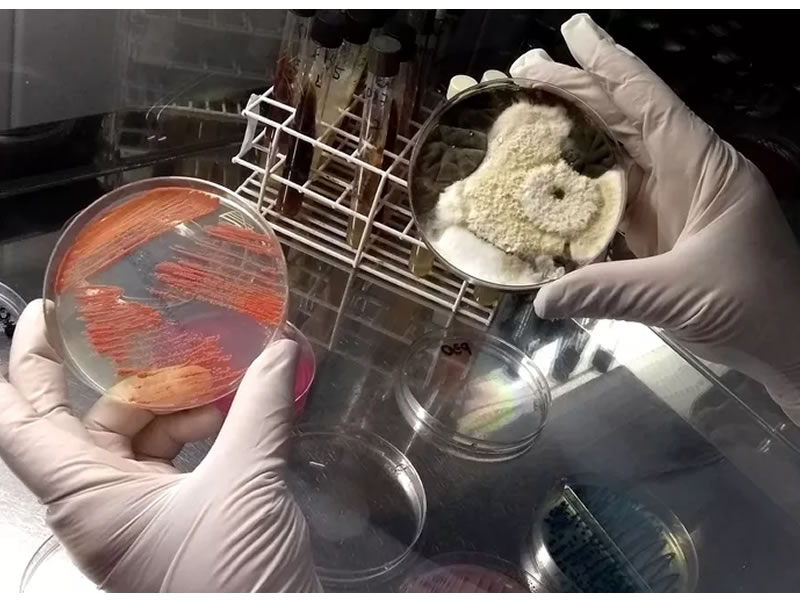
/14930saud1127.jpg

Editoria Saúde

Por que engordamos quando ficamos mais velhos (e não tem a ver só com o metabolismo)
Há causas menos conhecidas que nos fazem ganhar peso ao envelhecermos; saib...

Causa da sua gastrite pode ser problema pouco falado, mas bem fácil de tratar
A mucosa que reveste o estômago, que a deixa vulnerável a danos e inflamaçõ...

O que você precisa saber sobre a terapia que previne o HIV, que começará a ser oferecida no Brasil
SUS irá dispobilizar PrEP, a profilaxia pré-exposição, a partir deste mês p...

Quando uma infecção de dente pode gerar problemas no coração ou no cérebro?
Mesmo sentindo dores e desconfortos nos dentes, muitas pessoas minimizam o ...

Especialistas, no entanto, apontam para uma tendência de aumento em 2017.
Mundo registrou 5 milhões de casos a mais em um ano, interrompendo tendênci...

Pesquisa preliminar aponta que 54,6% dos brasileiros de 16 a 25 anos têm HPV
Estudo é composto por 5.812 mulheres e 1.774 homens. Foram incluídos dados ...
Pesquisa em roupas íntimas encontra 10 mil bactérias e fungos com risco de infecções; médicos fazem alerta
Estudo feito na Faculdade devry Metrocamp, em Campinas, abrangeu cuecas, ca...

Dr. José Bento: 4 casos em que mulher acha não ter risco de engravidar, mas está errada
Existem mitos acerca da fertilidade em diferentes períodos do ciclo reprodu...

Mulheres recebem menos massagem cardíaca e correm mais riscos: 2 causas preocupam
Os pesquisadores acreditam que, além da falta de treinamento, o receio de t...

Nova pílula promete deixar você escolher quando quer menstruar: é assim mesmo?
Um novo anticoncepcional que acaba de ser lançado promete deixar que a usuá...

Ferida no colo do útero é perigoso? Como identificar e tratar o problema?
#Saúde da Mulher.Popularmente conhecida como ferida no colo do útero, a ect...

9 alimentos que acalmam o estômago e espantam a azia e queimação
Pessoas que sofrem de azia e queimação aprendem logo quais são os alimentos...

Caju é fonte de vitamina essencial para combater infecções e aumentar a imunidade
Boa fonte de fibras solúveis, que garantem saciedade e bom funcionamento do...

Excesso de peso aumenta risco de cegueira: entenda a relação e como evitá-la
Doenças cardíacas, problemas renais, riscos de acidente vascular cerebral (...

5 sinais precoces de autismo em criança pequena: afeta jeito de comer e se relacionar
O autismo é um transtorno de desenvolvimento neurológico que pode ser perce...

Estalar os dedos, roer unhas, dormir pouco e mais 4 hábitos que arruínam sua saúde
Aparentemente inocentes e casuais, alguns hábitos do dia a dia podem ser ba...

O que a infecção generalizada realmente faz com o corpo? Por que é tão grave?
Quando uma infecção se torna generalizada,ou seja, se espalha por todo o co...

Comer queijo pode ajudar quem tem insônia a dormir melhor: veja como consumir
Durante muito tempo o queijo foi considerado um vilão de uma boa noite de s...
Nós usamos cookies e outras tecnologias semelhantes para melhorar a sua experiência em nossos serviços, personalizar publicidade e recomendar conteúdo de seu interesse. Ao utilizar nossos serviços, você concorda com tal monitoramento. Informamos ainda que atualizamos nossa




